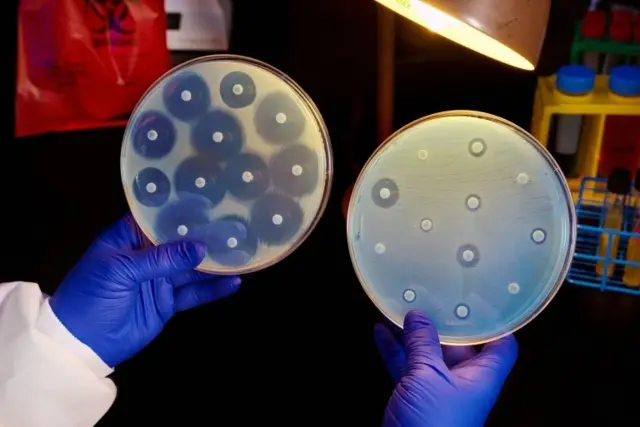
एन्टिबायोटिक कति प्रभावकारी भनेर गरिने परीक्षण

एन्टिबायोटिक: जथाभाबी औषधि प्रयोग गर्ने क्रम बढ्दो, किन त्यो गर्नुहुँदैन

तस्बिर स्रोत, Science Photo Library
सरकारले बिहीवारदेखि एक साताका लागि देशका सातवटै प्रदेशमा 'एन्टिमाइक्रोबियल'बारे सचेतना कार्यक्रम सुरु गरेको छ।
ब्याक्टेरिया, भाइरस र ढुसीजस्ता सूक्ष्मजीवविरुद्ध प्रयोग गरिने एन्टिबायोटिक, एन्टिभाइरल, एन्टिफङ्गल औषधिलाई एन्टिमाइक्रोबियल भनिन्छ।
यस्ता औषधिको अवाञ्छित प्रयोग हुँदा लक्षित सूक्ष्मजीवले प्रतिरोध क्षमता विकास गर्ने र तिनले गराउने रोग निको नहुने तथा बिरामीको मृत्यु पनि हुन सक्ने चिकित्सकहरूले बताएका छन्।
त्यसैले यसलाई गम्भीर रूपमा लिनुपर्ने विज्ञहरूको धारणा छन्।
चिकित्सकको सल्लाहबिना नै बिरामीले आफैँ वा औषधि पसलबाट किनेर एन्टिमाइक्रोबियल औषधि प्रयोग गर्दा टाइफोइड र औलोजस्ता रोग लाग्दा पनि बिरामीको उपचार गर्न कठिन हुने गरेको अनुभव चिकित्सकहरू सुनाउँछन्।
शुक्रराज ट्रपिकल तथा सरुवा रोग अस्पतालका प्रमुख कन्सल्टेन्ट डा. अनुप बाँस्तोला भन्छन्, "ब्याक्टेरियाबाट हुने सङ्क्रमणलाई कुनै पनि औषधिले काम नगर्ने वा कोभिडकै बिरामीलाई पनि उपचार गर्दा औषधिले काम नगरेका थुप्रै घटनाहरू हामीले देखिरहेका छौँ।"।
स्वास्थ्य तथा जनसङ्ख्या मन्त्रालयअन्तर्गत रहेको गुणस्तर मापन तथा नियमन महाशाखाका प्रमुख डा. मदनकुमार उपाध्याय पनि जथाभाबी औषधि प्रयोग गर्दा त्यसले रोग निको पार्न कठिन हुनेदेखि बिरामीको जीवनरक्षा गर्नै नसकिने घटना धेरै पटक देखिएको बताउँछन्।
उनले भने, "घरमै बसेर सामान्य औषधि खाए निको हुने टाइफोइडको बिरामीलाई बढी डोजसहित सुई दिनुपर्ने, लामो समय अस्पतालमै भर्ना गर्नुपर्ने र कतिपय अवस्थामा त कलेजोमा असर गरेको देखिन्छ। मस्तिष्कमा पनि असर गर्न सक्छ।"
एन्टिबायोटिकको प्रयोग बढिरहँदा त्यसले बिरामीको ज्यानै गएका घटना पनि धेरै देखिएको उनले बताए।

तस्बिर स्रोत, Science Photo Library
सचेतना कार्यक्रम किन?
एन्टिबायोटिकको अनुचित प्रयोगले कतिपय सङ्क्रामक जीवाणुहरूले औषधि प्रतिरोध गर्ने क्षमता अर्थात् 'एन्टिबायोटिक रेजिस्टन्स' विकास गरेको भन्दै विश्वव्यापी रूपमा चिन्ताहरू व्यक्त हुँदै आएका छन्।
नेपालमा पनि एन्टिबायोटिकको प्रयोग धेरै हुने गरेको तथ्याङ्कले नै देखाएका कारण सचेतनाको आवश्यकता परेको स्वास्थ्य मन्त्रालयको गुणस्तर मापन तथा नियमन महाशाखाले जनाएको छ।
महाशाखाका प्रमुख डा. उपाध्याय भन्छन्, "रोगसँग प्रति जैविक प्रतिरोध क्षमता घटेको तथ्याङ्कले देखाएको हुनाले यसबारे एक किसिमले आममानिसलाई, औषधि सुझाउने व्यक्ति र नीतिनिर्मातालाई सचेत गराउन ... यो कार्यक्रम गरेका हौँ।"
उनका अनुसार अहिले भइरहेका एन्टिबायोटिक औषधिहरूको प्रभावकारिता कम देखिन थालेको मात्रै नभई नयाँ औषधि पनि पत्ता लागेको छैन।
उनी भन्छन्, "अहिलेको अवस्थामा हामीसँग भएकै एन्टिबायोटिकहरूलाई भविष्यमा पनि प्रयोग गर्नुपर्ने कारणले तिनीहरूलाई सुरक्षित राख्नलाई पनि यसको प्रयोगबारे आममानिसले थाहा पाउन आवश्यक छ।"
तस्बिर स्रोत, Science Photo Library
सात वर्षअघि नै निर्देशिका
स्वास्थ्य तथा जनसङ्ख्या मन्त्रालयले रोगअनुसार तल्लो तहका स्वास्थ्य चौकीदेखि ठूला अस्पतालहरूले कुन अवस्थामा एन्टिबायोटिक सिफारिस गर्न पाउने भन्नेबारे २०७१ सालमै मापदण्ड तयार पारेको थियो।
चिकित्सकको परामर्शका आधारमा मात्र एन्टिबायोटिकको विक्रीवितरण गर्नका लागि उक्त निर्देशिका ल्याइएको बताइन्छ। तर नयाँ नियम लागु गरिएको भए पनि जथाभावी विक्रीवितरण बढ्दै गएको तथ्याङ्कले नै देखाउने महाशाखाले नै जनाएको छ।
उक्त निर्देशिकाले एन्टिबायोटिक सिफारिस गर्दा त्यसको अनावश्यक प्रयोग नहोस्, त्यसले कुनै असुरक्षा ननिम्त्याओस् र कम खर्चमा उपचार होस् भन्नेमा ध्यान दिन चिकित्सकहरूलाई सुझाव दिएको थियो।
निर्देशिकाले स्वास्थ्यसंस्थाहरूलाई उपलब्ध भौतिक संरचना र जनशक्तिका आधारमा तीन तहमा वर्गीकरण गरेको छ।

तस्बिर स्रोत, Science Photo Library
निर्देशिकाअनुसार स्वास्थ्य चौकीले आधारभूत औषधि मात्र सिफारिस गर्ने, प्राथमिक स्वास्थ्य केन्द्र र जिल्ला अस्पतालले केही एन्टिबायोटिक सिफारिस गर्न पाउने र विशेषज्ञसेवा दिने मध्यम स्तरका अस्पतालहरूले आधारभूत औषधिमा जोड दिनुपर्न भन्ने उल्लेख छ।
तर मध्यम स्तरका अस्पतालहरूले बिरामीको आवश्यकताअनुसार एन्टियाबायोटिकहरू सिफारिस गर्न सक्ने भन्ने पनि उक्त निर्देशिकामा उल्लेख छ।
महाशाखाका प्रमुख उपाध्यायका अनुसार अहिले उक्त निर्देशिका संशोधन गरिँदैछ।

तस्बिर स्रोत, RSS
पञ्चवर्षीय कार्ययोजना
सात वर्षअघि नै निर्देशिका तयार भएको र प्रत्येक वर्ष सचेतनाका कार्यक्रम गरिने भए पनि यसबारे सर्वसाधारण मानिसहरू जागरुक नभएको बताइन्छ।
त्यसबारे उपाध्याय भन्छन्, "यसमा सरकारले गरेर मात्रै हुँदैन। यो एन्टिबायोटिक रेजिस्टन्स जनस्वास्थ्य मात्रै होइन पशुस्वास्थ्यदेखि लिएर प्राकृतिक रूपमा हरेक कुरामा असर पर्ने हुनाले त्यसको लागि राष्ट्रिय कार्ययोजना अनुमोदन हुने क्रममा छ।"
उक्त पञ्चवर्षीय कार्ययोजना कार्यान्वयनका लागि स्वास्थ्यसचिवको संयोजकत्वमा एउटा समिति पनि रहेको उपाध्यायले बताए।
एन्टिबायोटिकको अत्यधिक र जथाभाबी प्रयोगलाई रोक्न ढिला भइसकेको डा. अनुप बाँस्तोला बताउँछन्।
उनले भने, "अर्को पुस्तालाई जोगाउनका लागि आजकै मितिबाट हामीले एन्टिबायोटिकको प्रयोग वैज्ञानिक र बिरामीको मूल्याङ्कन अनि आवश्यकताको आधारमा गर्नुपर्छ र जथाभावी प्रयोगलाई कडाइका साथ रोक्नुपर्ने म देख्छु।"
यो पनि हेर्नुहोस्
























